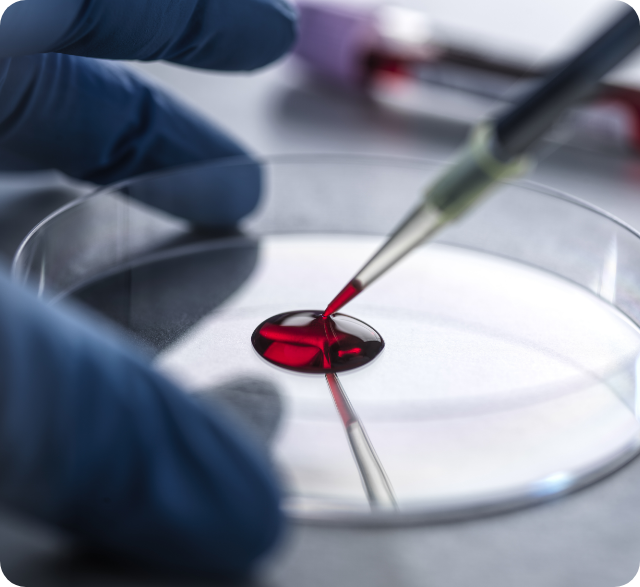
알레르기 검사

EM365 Medical Center
소아청소년과

ABOUT CLINIC
우리 아이의 건강한 모습을 위하여
용인이엠365가 매일 책임지겠습니다.
유아기부터 청소년기까지 항상 건강하게 자랄 수 있도록
정기적인 검진이 필요합니다.
Pediatric Clinic
소아청소년 건강검진
-
1
기본검사
안질환, 귓병, 콧병, 목병
혈압 검사 -
2
소변검사
요단백, 요잠혈 등의
검사 -
3
흉부 X-ray
결핵 및 순환기 계통의
검사 -
4
혈액검사
백혈구, 빈혈, 염증 수치,
백혈구 분포 등 검사 -
5
비만도 검사
혈당, 지질 검사, 중성지방
간기능검사
Pediatric Clinic
소아청소년 알레르기 검사
*MAST 검사 로 많은 알레르기 원인 물질 120종을 동시에
확인할 수 있습니다.
알레르기 반응을 일으키는 물질에 노출될 때에 반응을
측정하여 알레르기를 일으키는 물질을 확인하는 검사입니다.
-
소량의 혈액으로 검사 가능
-
영유아 검사도 가능
-
약물 영향 없는 객관적인 결과
-
국내 최다 알레르기 원인 물질 선별 가능
-
부작용 및 쇼크 위험성 배제
Pediatric Clinic
소아청소년 유행성 질환 치료
수족구, 독감, 폐렴, 감기 등 소아청소년의 유행성 질환을 진료하고
체계적으로 치료할 수 있도록 도와드리고 있습니다.
-
01
수족구
-
02
독감
-
03
폐렴
-
04
감기
EM 365 Medical Point
용인이엠365의원 진료 포인트
-
01
외래 진료 경험과 노하우가 풍부한 전문 의료진 365일 진료 -
02
응급실보다 적은 비용 & 짧은 대기 빠른 진료 가능 -
03
당일 검사 및 결과 확인 가능한 대학병원급 원내 임상 병리 -
04
여러 곳을 방문할 필요 없는 한 번의 방문으로 다양한 진료와 검사가 가능한 토탈 의원